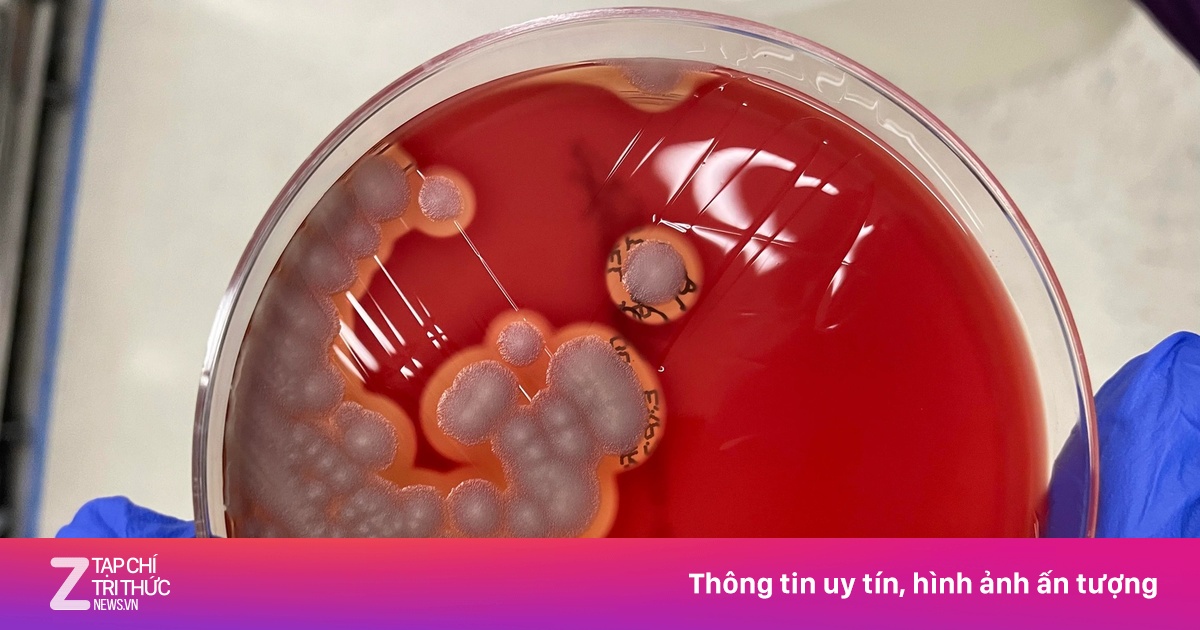

Sau bữa ăn bán trú tưởng chừng an toàn, 40 học sinh Trường Phổ thông Dân tộc Bán trú Tiểu học Kim Thủy (xã Kim Ngân, tỉnh Quảng Trị) phải nhập viện cấp cứu với các biểu hiện đau bụng, nôn ói.
Kết quả xét nghiệm từ Viện Pasteur Nha Trang khiến nhiều người bất ngờ: trong 4 mẫu thức ăn kiểm nghiệm, một mẫu dương tính với vi khuẩn Bacillus cereus - thủ phạm gây ra nhiều vụ ngộ độc thực phẩm lớn tại Việt Nam.
 |
| 40 học sinh trường PTDTBT Tiểu học Kim Thủy phải nhập viện sau bữa ăn tại trường nghi do ngộ độc. Ảnh: VTC News. |
Loại vi khuẩn "sống sót" dù đã được nấu chín
Bác sĩ chuyên khoa II Bùi Trọng Hợp, Trưởng khoa Nhiễm, Bệnh viện Trưng Vương (TP.HCM), cho biết Bacillus cereus là trực khuẩn Gram dương, tồn tại phổ biến trong môi trường như đất, bụi, cây cỏ, không khí và thực phẩm. Loại vi khuẩn này tiết ra độc tố gây nôn, tiêu chảy, đôi khi dẫn tới hoại tử mô hoặc tổn thương cơ quan nội tạng nếu nhiễm lượng lớn.
Thông thường, hệ vi sinh đường ruột của con người đủ mạnh để ức chế Bacillus cereus. Tuy nhiên, nếu ăn phải lượng lớn vi khuẩn - ước tính khoảng một triệu tế bào sống, sự cân bằng vi sinh bị phá vỡ, khiến người ăn ngộ độc cấp tính.
Đặc biệt, Bacillus cereus có khả năng "ngủ đông" trong dạng bào tử, giúp chúng sống sót sau khi bị đun nấu ở nhiệt độ cao. Khi thức ăn nấu chín được để nguội ở nhiệt độ phòng (10-45°C), các bào tử này có thể "tỉnh dậy" và sinh sôi nhanh chóng, khiến món ăn tưởng an toàn lại trở thành nguồn lây độc tố.
Ông Phạm Ngọc Hà, Viện Kiểm nghiệm An toàn Vệ sinh Thực phẩm Quốc gia, cho hay Bacillus cereus từng là nguyên nhân của nhiều vụ ngộ độc thực phẩm nghiêm trọng tại Việt Nam.
Năm 2020, hơn 230 người ở Đà Nẵng bị ngộ độc sau khi ăn đồ chay nhiễm E. coli, Staphylococcus aureus và Bacillus cereus. Trước đó, hàng chục trẻ mầm non ở Cần Thơ nhập viện vì ăn phở và sữa chua nhiễm cùng loại vi khuẩn này.
 |
| Bacillus cereus có khả năng "ngủ đông" trong dạng bào tử, giúp chúng sống sót sau khi bị đun nấu ở nhiệt độ cao. Ảnh: Chromagar. |
Đáng chú ý nhất là vụ việc năm 2022 tại trường iSchool Nha Trang: hơn 600 học sinh nhập viện, một em không qua khỏi. Kết quả kiểm nghiệm của Viện Pasteur Nha Trang cho thấy cánh gà chiên và nước mắm chứa đồng thời Bacillus cereus, Salmonella và E. coli.
Kháng kháng sinh và khó điều trị
Theo bác sĩ chuyên khoa II Bùi Trọng Hợp, Bacillus cereus thuộc nhóm vi khuẩn Gram dương, nên không nhạy với nhiều loại kháng sinh phổ biến điều trị tiêu chảy như quinolone hoặc cephalosporin.
"Nếu bác sĩ kê sai thuốc, bệnh nhân có thể diễn tiến nặng hơn vì vi khuẩn này không bị tiêu diệt", bác sĩ Hợp nhấn mạnh.
Người nhiễm Bacillus cereus thường xuất hiện đau bụng, buồn nôn, tiêu chảy sau khi ăn từ 4 đến 16 giờ. Các triệu chứng kéo dài 12-24 giờ, đôi khi gây nôn mửa sớm chỉ 1-6 giờ sau bữa ăn nhiễm khuẩn.
Theo Viện Sức khỏe Quốc gia Mỹ (NIH) và Trung tâm Kiểm soát và Phòng ngừa Dịch bệnh Mỹ (CDC), để xác định ngộ độc do Bacillus cereus, bác sĩ có thể xét nghiệm chất nôn, phân hoặc mẫu thực phẩm, sau đó so sánh chủng vi khuẩn tìm thấy với mẫu ô nhiễm.
Tại Việt Nam, các phòng xét nghiệm hiện sử dụng phương pháp nuôi cấy truyền thống, định lượng bằng kỹ thuật đếm khuẩn lạc ở 30°C theo tiêu chuẩn TCVN 4992:2005 (ISO 7932:2004). Bên cạnh đó, kỹ thuật PCR, Real-time PCR và định danh gen 16S bằng MALDI-TOF giúp nhận diện chính xác chủng gây bệnh.
 |
| Tại Việt Nam, các phòng xét nghiệm hiện sử dụng phương pháp nuôi cấy truyền thống, định lượng bằng kỹ thuật đếm khuẩn lạc, PCR, Real-time PCR và định danh gen... Ảnh minh họa: Việt Linh. |
Theo các chuyên gia, Bacillus cereus tồn tại rộng rãi trong môi trường tự nhiên. Ngộ độc thực phẩm do loại vi khuẩn này thường xảy ra khi các khâu từ nguyên liệu, sơ chế, chế biến, bảo quản đến vận chuyển và kiểm tra chất lượng không được kiểm soát chặt chẽ.
Những thực phẩm dễ bị nhiễm loại vi khuẩn này bao gồm sữa và các sản phẩm từ sữa, thịt, rau củ, gia vị, thực phẩm khô, đặc biệt là các món làm từ ngũ cốc như bánh mì, cơm, pizza hay hạt ngũ cốc.
Để phòng bệnh, người dân cần tuân thủ nghiêm nguyên tắc giữ thực phẩm ở nhiệt độ an toàn:
Trẻ con đứa nào chẳng ốm
Trong quá trình nuôi con, cha mẹ không tránh khỏi lo lắng trước những hiện tượng liên quan đến sức khỏe của em bé. Trẻ có thể chảy nước mũi hay húng hắng ho khi chuyển mùa, gặp vấn đề tiêu hóa, bệnh đường tiêu hóa khi thời tiết thay đổi.
Những lúc ấy, các bậc phụ huynh sẽ đưa con đến thẳng bệnh viện để nhờ bác sĩ thăm khám, nghe theo những phương thuốc dân gian hay quáng quàng lo lắng? Trẻ con đứa nào chẳng ốm, Để con được ốm hay Hỏi bác sĩ nhi đồng sẽ là cẩm nang chăm sóc sức khỏe cho trẻ, cung cấp kiến thức khoa học về chăm sóc sức khỏe trẻ em.